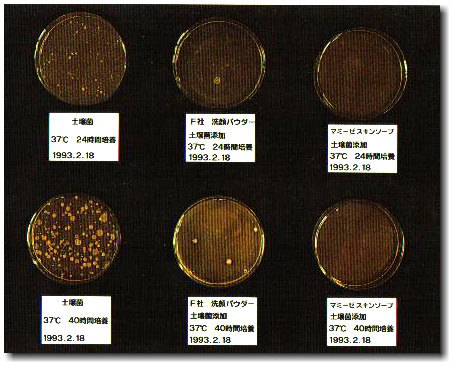
mammy.jpg

乳清ってなあに?
 こんにちは
こんにちは私は乳清生まれの『マミーゼ』のマミちゃんです。
「ゼ」は「是」、道理にかなった正しいもの、という意味です。
母乳の神秘、乳清の力を最大限に生かした乳清スキンケアは、
お母さん(マミー)のやさしさ、強さが込められ、理にかなっている(ゼ)・・・・ だから、『マミーゼ』です。
名前の通りの『マミーゼ』の自信をご案内します。
●乳酸菌発酵液です。ヨーグルトを食べる時できる上ずみ液、あれが乳清です。
●母乳成分に非常に近く、 たんぱく質、ビタミン、ミネラル、多糖類など、栄養素が豊富です。皮膚細胞を構成している成分に非常に近いのでお肌に負担をかけることなく、お肌に自然になじみ、保湿力を高める働きがあります。
●乳清利用の歴史は古く、古代ギリシャ医学の偉大なる医師ヒポクラテスが乳清療法を取り入れていたのは有名です。『水薬』と呼ばれ、身体内の清浄や機能回復に使われていました。 又、乳清がお肌を若々しく保つことで知られ、古代ヨーロッパでは乳清風呂など、上流夫人の美容にも使われていました。
●最近もヨーグルトパックというのが流行りましたよね。ちなみに、ヨーグルトの上ずみ液は栄養豊富な乳清ですから、捨てないでしっかり飲みましょうね。
“乳清”のすばらしい特徴とは?
1.安全性
母乳に近い乳清の成分は、皮膚細胞を構成している成分と非常に近く皮膚に負担をかけません。
2.保湿力
つけるごとに保湿効果が高まります。
乳清はうるおい成分として、もっとも理にかなった理想の成分です。それは乳清が完全栄養と言われる母乳成分に非常に近く、皮膚細胞を構成して入る成分に近いからです。皮膚本来の働き、自立活性が高まり、皮脂腺が正常になり、天然のうるおいを導き出します。
3.抗酸化能で老化防止
乳清(ラクトフェリン)がたっぷり含まれているマミーゼです。“ラクトフェリン”は母乳、特に出産後初めて出てくる初乳に多く含まれる生理活性物質で、著しく高い抗酸化能(活性酸素消去物質=SODと同様の働き)と、皮膚本来の防御機能を高める働きを持っています。
ラクトフェリンの働きは
(1)肌の老化の原因である酸化の進行を止める。
(2)皮膚本来の防御機能を高める。
(3)酸化によって引き起こされる炎症を押さえる。
●リン脂質、表皮脂質などの脂質酸化により、保水力低下から肌荒れ、乾燥を引き起こします。
●コラーゲン、エラスチンなどの細胞間物質のたんぱく質酸化により、肌弾力低下からシワやくすみ、たるみの原因になります。
4.静菌作用
乳清に含まれる”ラクトフェリン”というたんぱく質が、鉄との結合作用によって、細菌の育成に必要な鉄を細菌に渡さず、そのために細菌は育成できなくなります。マミーゼは乳清の静菌作用とヒノキチオールの天然の抗菌作用の相乗効果で防腐剤無添加を可能にし、腐敗、変質を抑えています。
5.異物浄化作用
乳清には老廃物や異物を浄化する働きがあります。
乳清に含まれるラクトフェリンの静菌作用と天然樹脂から抽出したヒノキチオールの天然抗菌作用の相乗効果で、腐敗、変質を抑えています。
 ハーイ、マミちゃんで~す。 ニキビ花盛りの中学生、高校生の皆さーん、・・・・・・足がクサーイ(失礼)とお子さんから顔をそむけられるお父さん、体臭が気になる人、マミーゼスキンソープを頼りにしてくださーい。乳清の精菌作用と異物浄化作用のすぐれた働きで、汚れやニオイのみを取り除き、毛穴を清潔にして菌を繁殖させません。・・・・・ もうマミーゼスキンソープが手放せなくなりますよ。
ハーイ、マミちゃんで~す。 ニキビ花盛りの中学生、高校生の皆さーん、・・・・・・足がクサーイ(失礼)とお子さんから顔をそむけられるお父さん、体臭が気になる人、マミーゼスキンソープを頼りにしてくださーい。乳清の精菌作用と異物浄化作用のすぐれた働きで、汚れやニオイのみを取り除き、毛穴を清潔にして菌を繁殖させません。・・・・・ もうマミーゼスキンソープが手放せなくなりますよ。ラクトフェリン(たんぱく質)が鉄との結合作用によって、細菌の育成に必要な鉄を細菌に渡さず、そのために細菌は育成できなくなります。
※「ラクトフェリン」は母乳の初乳たんぱく質の7割を占め、各種細菌に対する作用の実験で、有害菌にたいしては抗生物質に劣らない抗菌作用が確認されています。またビフィズス菌など有益菌には作用しないという、まさにこれが母乳の神秘、不思議というもので、この画期的な「ラクトフェリン」の解明により、様々の分野で応用されています。
「ラクトフェリン」を育児用粉ミルクに応用しているのをはじめ”夢の医薬品”開発にも期待されています。
※この母乳の神秘をスキンケアに応用して完成したのがマミーゼです。
自然や健康への志向が高まる中、ヒバ、ヒノキ生まれのヒノキチオールの天然の抗菌作用が今注目されています。ヒノキチオールが含まれる青森ヒバは、昔から腐りにくく、シロアリなどが寄り付かない木として知られ、建物の土台や水回りなどに利用されました。
化学物質ではなく、人体に悪影響のない天然物質、ヒノキチオールの抗菌、防腐、防虫効果は様々な分野で注目され応用されています。
※ マミーゼは、菌の繁殖を抑える乳清の静菌作用と相乗効果をもたせることで、防腐剤無添加を可能にしています。
※ヒノキチオールはアトピー性皮膚炎に有効と確認されています。又、社会問題化している院内感染の予防にも有効と研究報告されています。どちらにも、その原因となるメチシリン耐性黄色ブドウ球菌(MRSA)に対してヒノキチオールの抗菌作用が有効に働き、MRSAを増殖させない効果が認められています。アトピー性皮膚炎の湿疹病巣の9割に黄色ブドウ球菌が存在するといわれています。
※アトピー性皮膚炎の方と院内感染予防のために、天然の抗菌効果と安全性の両面で、安心のマミーゼをおすすめします。 ①マミーゼスキンソープで全身洗いや手洗い。 ②マミーゼローションやシルクローションで保湿。(どちらかひとつなら、シルクローションを)
■菌の培養実験■
左は土壌菌、中は他社無添加化粧品、右はマミーゼ
シャーレの中の斑点が菌です。
マミーゼは、全く菌が繁殖しないことがわかります。